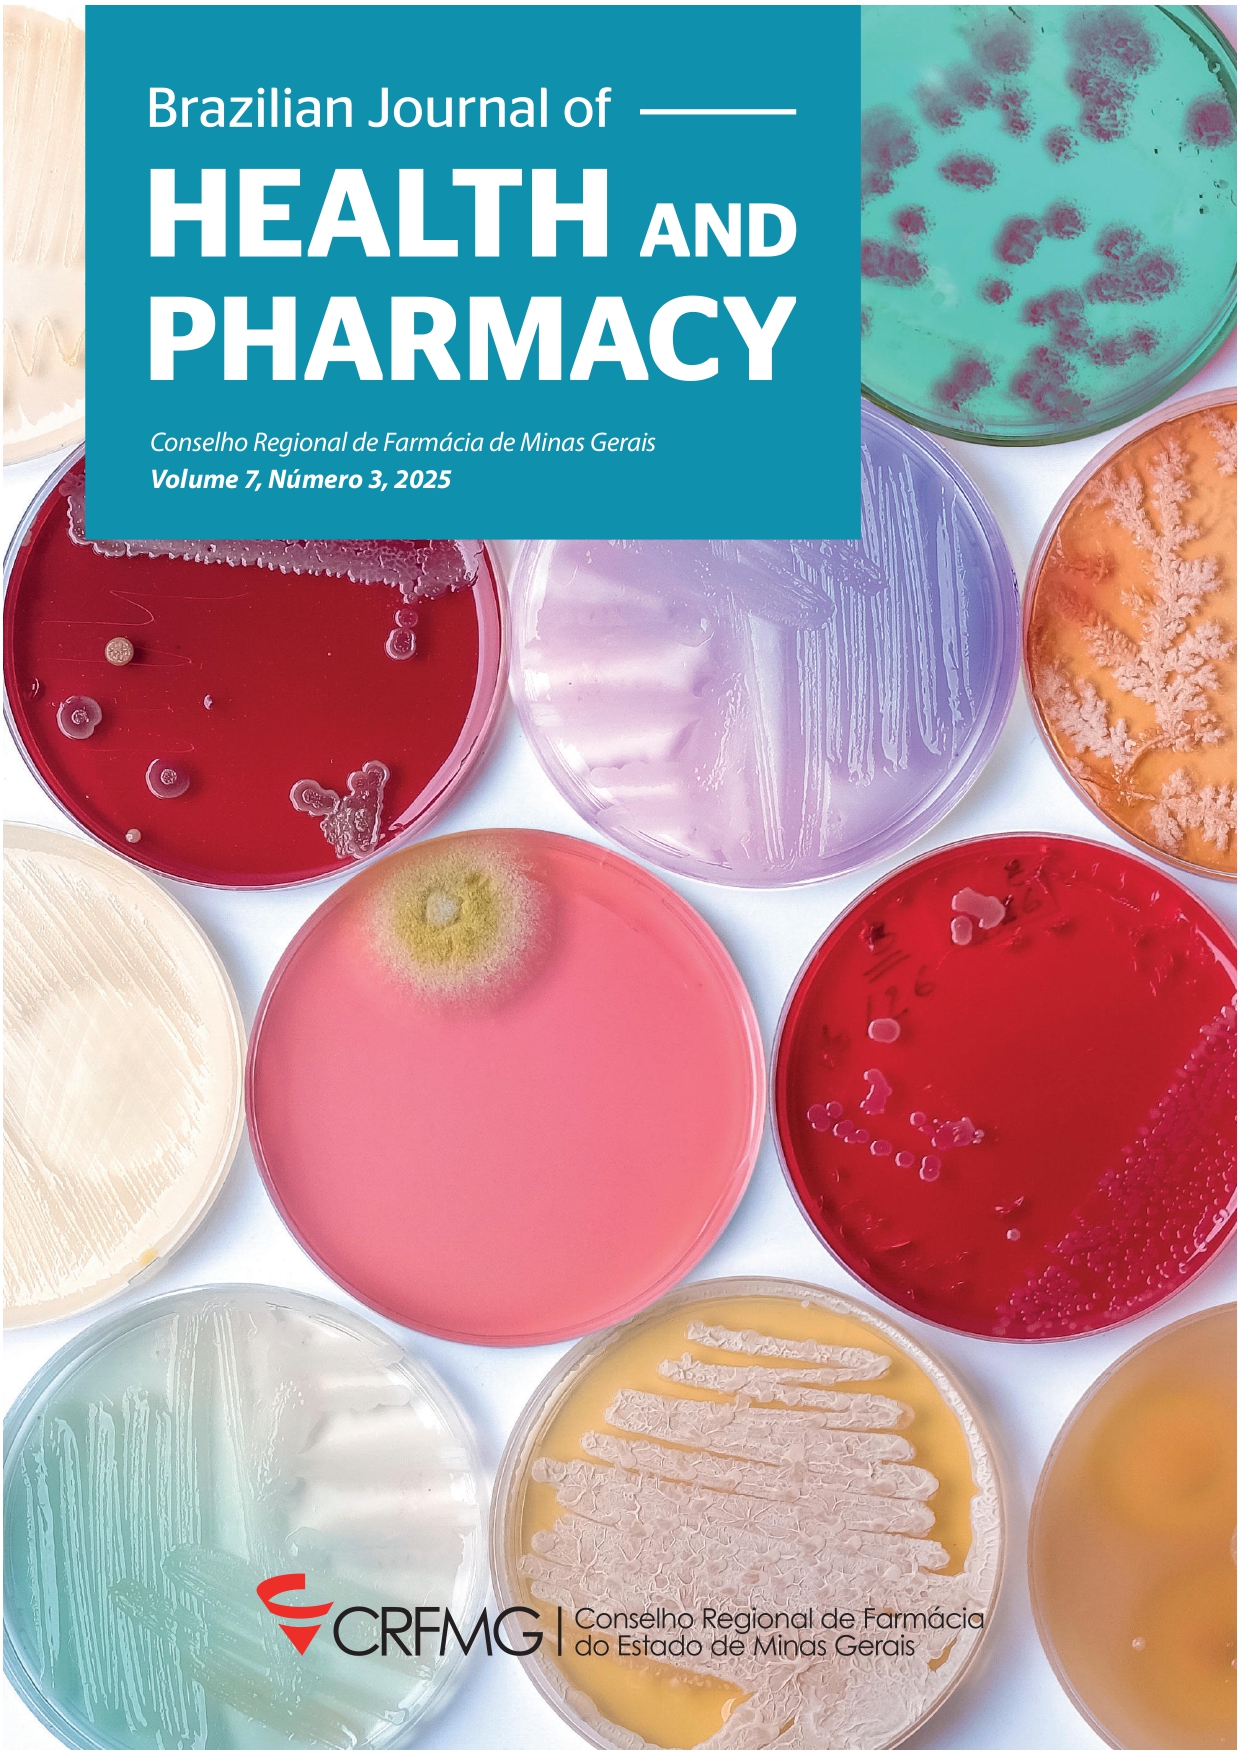

Resumo
A olanzapina (OLZ) é um fármaco antipsicótico de segunda geração indicada no tratamento da esquizofrenia e do transtorno bipolar, pertencente à classe II do Sistema de classificação biofarmacêutica. A baixa solubilidade aquosa da OLZ, associada à sua intricada natureza polimórfica e sensibilidade a certas condições ambientais como calor e umidade pode afetar a biodisponibilidade. Portanto, o objetivo deste estudo foi avaliar a influência das características físico-químicas (distribuição de tamanho de partícula, fluxo, molhabilidade, solubilidade e perfil de dissolução) de três diferentes amostras da matéria-prima OLZ de diferentes fabricantes de insumos farmacêuticos ativos (IFA) para determinar possíveis impactos na formulação e processabilidade. A partir dos resultados de pré-formulação, foi proposta uma formulação por compressão direta para o medicamento olanzapina 10 mg comprimido revestido. As formulações foram avaliadas quanto à conformidade com os ensaios previstos em compêndios oficiais, incluindo fluidez, desintegração, variação de peso, friabilidade, dureza e doseamento, juntamente com a avaliação da similaridade dos perfis de dissolução in vitro com o medicamento referência no mercado nacional. Notavelmente, a formulação manipulada com os três fabricantes diferentes apresentou resultados satisfatórios, corroborando os dados dos estudos de solubilidade e dissolução das matérias-primas. Os resultados demonstram a equivalência das formulações testadas em relação ao medicamento referência, nos meios de dissolução com pH na faixa fisiológica. Desta forma, para a olanzapina, as características físico-químicas do fármaco associadas à formulação proposta e processo produtivo apresentaram papel determinante no desempenho do produto na avaliação da equivalência farmacêutica.